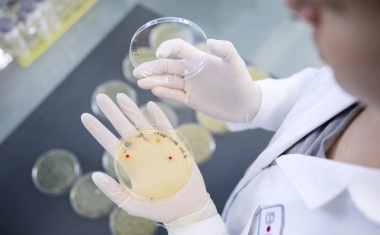

BRAIN Biotech ernennt Johan Jansén-Storbacka zum EVP BRAIN Biocatalysts Enzymprodukte
BRAIN Biotech hat Johan Jansén-Storbacka mit Wirkung zum 1. September 2025 zum Executive Vice President BRAIN Biocatalysts für den Bereich Enzymprodukte ernannt.

BRAIN Biotech hat Johan Jansén-Storbacka mit Wirkung zum 1. September 2025 zum Executive Vice President BRAIN Biocatalysts für den Bereich Enzymprodukte ernannt.

BRAIN Biotech konnte im dritten Quartal 2024/25 den Umsatz im Vergleich zum Vorjahr um 2,1% von 13,2 Mio. EUR auf 13,5 Mio. EUR steigern.

Corbion und BRAIN Biotech haben eine Vereinbarung zur Zusammenarbeit bei der Entwicklung neuartiger biobasierter antimikrobieller Verbindungen und deren Derivate getroffen.

Minderheitsübernahme von Breatec, Erweiterung des Kompetenzzentrums für Backapplikationen

BRAIN Biotech und die PX Group wollen im Rahmen der PX Urban Mining Initiative kooperieren. Die Ausweitung der Partnerschaft im Rahmen dieser Initiative ist das Ergebnis einer erfolgreichen Zusammenarbeit zwischen den beiden Unternehmen, bei der die Machbarkeit der biologischen Rückgewinnung von Gold aus Elektronikschrott und anderen goldhaltigen Nebenströmen gezeigt wurde.

BRAIN Biotech hat mit der Akribion Therapeutics einen exklusiven Technologie-Lizenzvertrag für die Genom-Editing-Nuklease G-dase E für den Pharmabereich abgeschlossen. BRAIN Biotech erhält bis zu 92,3 Mio. EUR von Akribion an F&E- sowie kommerziellen Meilensteinzahlungen für die Einräumung dieser exklusiven Rechte zur Nutzung im pharmazeutischen Feld.

BRAIN Biotech und Biocatalysts bündeln künftig ihre Kernkompetenzen in Form einer Initiative, um die Enzymentwicklung im Life-Science-Markt zu revolutionieren und die besonderen Herausforderungen im Zusammenhang mit heute bestehenden IP-Beschränkungen und Skalierung zu adressieren.

BRAIN Biotech, Tropical Viticulture Consultants, Zukunftsweine und die Provadis Hochschule entwickeln gemeinsam nachhaltige, alkoholfreie Getränke aus landwirtschaftlichen Seitenströmen

BRAIN Biotech und AMSilk haben die erste Phase einer Entwicklungskooperation erfolgreich abgeschlossen. Die Partner, die ihre Kooperation vor einem Jahr begonnen hatten, konnten ein natürliches Strukturprotein zielgerichtet optimieren und haben für dieses Verfahren ein erstes PCT-Patent angemeldet.

Die BRAIN Biotech AG hat die beiden letzten Minderheitsbeteiligungen an der Biocatalysts Ltd, Wales, erworben. Biocatalysts befindet sich nun vollständig im Besitz der BRAIN Biotech AG – Muttergesellschaft der BRAIN Biotech Gruppe – und wird den Kern der ehrgeizigen Wachstumsstrategie der Unternehmensgruppe zur Bildung eines globalen Multi-Nischen-Enzymunternehmens bilden.

BRAIN Biotech hat im Rahmen des vierten Kapitalmarkttags (Capital Markets Day, CMD) Investoren über seine zukünftige Unternehmensstrategie informiert. Das Unternehmen sieht große Chancen in der Biotransformation der Wirtschaft und sieht sich gut positioniert, um von den starken globalen Nachhaltigkeitsinitiativen in den Bereichen Gesundheit, Ernährung und Umwelt zu profitieren.

Im Rahmen einer strategischen Kooperation bringen BRAIN Biotech und AMSilk ihre Expertise ein, um die Entwicklung leistungsfähiger Fasern für den Performance-Material-Markt voranzutreiben.

Nach der Ankündigung im Oktober 2022, wonach für die proprietäre CRISPR-Technologie der BRAIN Biotech ein unabhängiges Segment eingerichtet wird, gibt die Konzernleitung nun bekannt, dass Alexander Pelzer ab sofort die Nachfolge von Michael Krohn als Leiter Forschung & Entwicklung antreten wird. Michael Krohn wird sich nun voll und ganz auf seine neue Führungsrolle bei Akribion Genomics konzentrieren.

BRAIN Biotech und Bonumose haben bekannt gegeben, dass sie im Rahmen ihrer strategischen Zusammenarbeit erste Projektmeilensteine erreicht haben. Ziel der Unternehmen ist es, die Leistungsfähigkeit verschiedener Enzyme zu verbessern, die in Reaktionskaskaden zur kontinuierlichen Produktion kalorienarmer, natürlich vorkommender seltener Zucker eingesetzt werden.

BRAIN Biotech hat die 9M-Zahlen für das Geschäftsjahr 2021/22 veröffentlicht. Nach einem sehr starken Start in das Geschäftsjahr setzt der Konzern seine hohe Umsatzdynamik auch im dritten Quartal fort.

BRAIN Biotech und Formo Bio starten eine strategische Zusammenarbeit, um die fermentative Herstellung tierfreier Milchproteine weiter voranzubringen.

Die BRAIN Biotech übernimmt Breatec inklusive der Comix- Aktivitäten, Nieuwkuijk, Niederlande. Breatec ist ein erfolgreicher Distributor, Formulierer und Blender von funktionellen Lebensmittelzutaten für die Back- und Mühlenindustrie. Durch diese Akquisition werden der Wachstumskurs des BRAIN-Geschäftsbereichs BioIndustrial weiter beschleunigt und das Enzym-Portfolio auf angrenzende Marktsegmente erweitert.

Zehn Süßstoffe sind in der EU zugelassen, doch ungebrochen ist die Suche nach neuen natürlichen Alternativen. Brazzein ist ein besonderer Kandidat aus der Forschung.

Eine Forschungskooperation zwischen der BRAIN Biotech und dem Meeresforschungsinstitut SAMS soll mittels des Genom-Editing-Werkzeugs BEC neue Wege finden, um essenzielle Fettsäuren nachhaltiger und kostengünstiger herzustellen.

Sartorius und BRAIN Biotech erforschen und adaptieren gemeinsam neuartige CRISPR-Cas-Genom-Editing-Nukleasen für spezielle Applikationen im Bereich Life-Sciences.
Die positiven Ergebnisse kürzlich durchgeführter Experimente haben das Vertrauen des Managements der BRAIN Biotech in die starke IP-Position ihrer neuartigen Genome-Editierungs-Nuklease BRAIN-Engineered-Cas (BEC) weiter erhöht.

BRAIN Biotech hat ihre Beteiligung an dem erfolgreichen Enzymproduzenten Biocatalysts in Wales durch den Erwerb weiterer Anteile von Minderheitsaktionären auf 82,2% ausgebaut. Aufgrund der starken Geschäftsentwicklung bei Biocatalysts werden die derzeitigen Produktionskapazitäten bald voll ausgelastet sein, obwohl sie erst Anfang 2021 in Betrieb gingen. Die zweite Ausbauphase soll daher vorgezogen werden.

BRAIN Biotech hat die erste Entwicklungsphase für ein neuartiges CRISPR Cas-System zur Genom-Editierung erfolgreich abgeschlossen und dabei ihre fortschrittlichen Fähigkeiten in den Bereichen Metagenom Sequenzierung und Protein Engineering zur Anwendung gebracht.

Roquette, ein weltweit führendes Unternehmen auf dem Gebiet der pflanzlichen Inhaltsstoffe für Lebensmittel-, Ernährungs- und Gesundheitsmärkte, das Biotech-Unternehmen BRAIN und das BRAIN-Gruppen-Mitglied AnalytiCon Discovery haben die F&E-Phase zur Entwicklung von Brazzein erfolgreich abgeschlossen. Nun haben die Partner eine vertragliche Vereinbarung für die Zulassung und die Produktion getroffen.

BRAIN hat heute den Kauf der Biosun Biochemicals mit Sitz in Tampa, Florida, bekanntgegeben. Das Unternehmen agiert auf dem US-Markt als erfolgreicher Distributor, Formulierer und Mischer von Enzymen, Aromen, Lebensmittelinhaltsstoffen sowie natürlichen Farbstoffen. Der Kauf wird den Wachstumskurs von BRAIN im Segment BioIndustrial weiter vorantreiben und die Vertriebskapazitäten von BRAIN in Nordamerika verbessern.

BRAIN hat heute ihre Ergebnisse der ersten neun Monate des Geschäftsjahrs 2019/20 veröffentlicht. Demnach verzeichnet die BRAIN-Gruppe einen Umsatz in Höhe von 29,6 Mio. EUR gegenüber 27,9 Mio. EUR in der Vorjahresperiode. Das entspricht unter Berücksichtigung der Entkonsolidierung der Monteil Cosmetics einem organischen Wachstum von 12,2%.

Heraeus Precious Metals und BRAIN haben eine Kooperation zur biologischen Rückgewinnung von Platingruppenmetallen (PGM) aus industriellen Prozessströmen erfolgreich und planmäßig abgeschlossen. Ziel der Kooperation war die Entwicklung eines biotechnologischen Verfahrens, mit dem sich die Platingruppenmetalle umweltfreundlich aus industriellen Prozessströmen rückgewinnen lassen.

Beim Biotech-Unternehmen BRAIN scheidet Chief Business Officer Ludger Roedder aufgrund unterschiedlicher strategischer Vorstellungen am 7. Juli 2020 aus dem Vorstand in gegenseitigem Einvernehmen aus. Roedder wird das Unternehmen zum Ende des Kalenderjahres verlassen.






